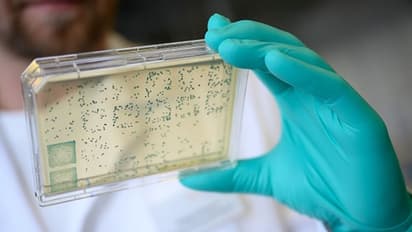
কোভিড সংক্রমণ উর্ধ্বমুখী রাজ্যের এই জেলাগুলিতে, ধীরগতিতে বাড়ছে সুস্থতার হার, দেখুন ছবি

কোভিড সংক্রমণ উর্ধ্বমুখী রাজ্যের এই জেলাগুলিতে, ধীরগতিতে বাড়ছে সুস্থতার হার, দেখুন ছবি
কোভিড গ্রাফ ফের উর্ধ্বমুখী কলকাতা সহ রাজ্যে। চিন্তা বাড়াচ্ছে এই ৩ জেলা। উত্তর ২৪ পরগণা, পশ্চিম মেদিনীপুর এবং দার্জিলিং। রাজ্যে সুস্থতার হারও দ্রত বৃদ্ধি পাচ্ছে না। এখনও আটকে ৯৭ এর ঘরেই। রবিবারের স্বাস্থ্য ভবনের বুলেটিন অনুযায়ী রাজ্যে এই মুহূর্তে একদিনে আক্রান্ত হয়েছেন, ১ হাজার ২৯৭ জন এবং মৃত্যু হয়েছে ২০ জনের। চলুন দেখে নেওয়া যাক বাংলা তথা কলকাতার কোভিড পরিস্থিতি ছবিতে-ছবিতে।
West Bengal News (পশ্চিমবঙ্গের খবর): Read In depth coverage of West Bengal News Today in Bengali including West Bengal Political, Education, Crime, Weather and Common man issues news at Asianet News Bangla.
click me!